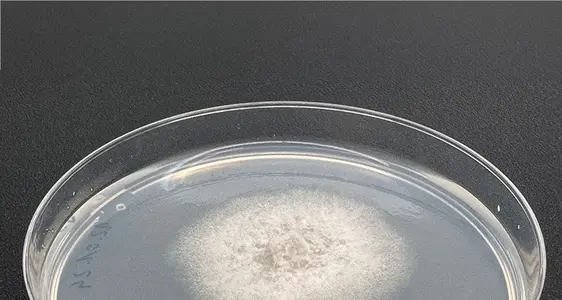
Un isolato di Colletotrichum chrysophilum su terreno di coltura.

Glomerella Leaf Spot
Fino a pochi anni fa, la patologia fungina Glomerella Leaf Spot (GLS) era limitata a singole regioni di coltivazione delle mele subtropicali in Sud America, nel sud-est degli Stati Uniti e in Cina. Nel 2019, questa patologia è stata rilevata per la prima volta nella regione italiana dell'Emilia-Romagna. Nel 2020 sono stati osservati per la prima volta i sintomi della malattia anche in meleti dell'Alto Adige. Il gruppo di lavoro Fitopatologia del Centro Laimburg è riuscito a rilevare e identificare il patogeno in tempi molto brevi (Oettl et al., 2021).
La patologia Glomerella Leaf Spot (GLS)
All'inizio dell'autunno 2020 è stata osservata una maggiore presenza di macchie fogliari necrotiche in singoli meleti dell'Alto Adige (Fig. 1). In breve tempo si è sviluppata anche una pronunciata clorosi delle foglie (Fig. 2) e nei frutteti colpiti è iniziata una massiccia e precoce caduta delle foglie. Quasi contemporaneamente, sui frutti sono comparse macchie bruno-rossastre della dimensione di una capocchia di spillo (Fig. 3), alcune delle quali leggermente infossate. Spesso si osservava un anello di colore viola (noto anche come alone) intorno al sito di infezione (Fig. 4). Entro un mese dalla comparsa delle prime macchie fogliari, gli alberi mostravano una defogliazione quasi completa (Fig. 5). Sebbene i sintomi ricordassero vagamente l’infezione da Alternaria, uno sviluppo così rapido dei sintomi era finora sconosciuto in Alto Adige. Il gruppo di lavoro Fitopatologia del Centro di Sperimentazione Laimburg ha immediatamente effettuato approfondite analisi di laboratorio per individuare la causa di questo danno.
Identificazione microbiologica e biomolecolare del patogeno
Nel laboratorio fitopatologico del Centro Laimburg, allo scopo di isolare il patogeno, sono stati prelevati campioni di tessuto dalle macchie necrotiche delle foglie e dei frutti e incubati su specifici terreni di coltura. Dopo alcuni giorni, nella maggior parte dei campioni era riconoscibile una morfologia fungina uniforme (Fig. 6). Mediante un’analisi microscopica delle spore fungine, gli isolati sono stati assegnati al genere Colletotrichum sp. Il sequenziamento di una specifica regione di DNA, cioè l’informazione genetica del fungo, ha portato a un'assegnazione preliminare al complesso di specie Colletotrichum gloeosporioides (ingl.: Colletotrichum gloeosporioides species complex; CGSC). Con ulteriori tecniche specifiche di laboratorio e un’analisi filogenetica con specie note, è stato possibile determinare in modo inequivocabile anche la specie del microorganismo presente in Alto Adige. Si tratta della specie Colletotrichum chrysophilum.
L'aumento della presenza di Glomerella Leaf Spot (GLS) nei meleti dell'Alto Adige
Dopo la prima comparsa della malattia GLS in Alto Adige nel 2020, nel 2021 non si sono registrati casi della patologia in Alto Adige. Nel 2022 è stata osservata solo una comparsa estremamente limitata e localizzata di GLS nei meleti in cui la malattia era già stata rilevata due anni prima. Invece, durante la fine dell'estate e l'inizio dell'autunno del 2023 è osservata un'ampia diffusione di GLS e un notevole allargamento dell'area colpita. La patologia è stata osservata in appezzamenti di fondovalle da Terlano a Merano. Tuttavia, si sono verificati casi isolati anche nella zona di Bolzano, nell'Oltradige e nella Bassa Atesina. Il livello di infestazione variava notevolmente, da poche macchie per frutto e pianta fino ad appezzamenti in cui la quasi totalità dei frutti presentava sintomi. Nelle osservazioni in campo, i sintomi erano più visibili sulle varietà Gala, Granny Smith e Cripps Pink(cpvr)-Rosy Glow(cpvr)-Sekzie(cpvr)/Pink Lady® e Golden Delicious, ma sono state riscontrate macchie sui frutti anche su CivM49(cov)/RedPop®, MC 38(cov)/Crimson Snow®, Ipador(cov)/Giga® e altre varietà. In letteratura, i discendenti da Golden Delicious sono descritti come suscettibili alla GLS, mentre le varietà derivanti da Red Delicious o da Fuji sono considerate tolleranti.
Le aree di coltivazione di mele extraeuropee, che hanno già una maggiore esperienza con la GLS, hanno riferito che, durante la conservazione, le macchie di GLS sui frutti rimangono limitate al sito di infezione e che non si verificano ulteriori sviluppi durante lo stoccaggio in cella frigo (premesso che le mele siano immagazzinate immediatamente a basse temperature). Le prime prove preliminari in Alto Adige confermano questa esperienza. Una possibile proliferazione delle macchie sui frutti durante la conservazione e lo shelf life col raccolto del 2023 sono attualmente oggetto di indagini scientifiche. Si attendono risultati più approfonditi dopo la rimozione del raccolto 2023 dalla cella frigo.
Stato della ricerca sulla GLS in Europa
Sebbene la GLS sia presente da qualche decennio in alcune regioni di coltivazione extraeuropee, non esistono informazioni scientificamente affidabili sulle condizioni di infezione e sull'epidemiologia locali a causa della sua finora limitata diffusione in Europa. Tuttavia, le segnalazioni di rilevamenti di GLS nell'autunno del 2023 in altre aree di produzione di mele italiane, come l’Emilia-Romagna, il Piemonte e occasionalmente il Trentino, indicano una diffusione crescente della patologia.Sulle cause dell'aumento dell'incidenza nella stagione vegetativa 2023 è possibile formulare solo ipotesi fino all'analisi conclusiva dei dati, ma si può ipotizzare che le precipitazioni abbondanti di fine estate, seguite da temperature costantemente oltre la media annuale, abbiano avuto un impatto significativo sull'incidenza dell'infezione.
Queste condizioni climatiche possono aver contribuito al fatto, che alla fine dell'estate 2023 è stato osservato per la prima volta in Alto Adige anche il marciume amaro del melo (ingl.: apple bitter rot; ABR) (Fig. 7). Come la GLS, anche questa patologia è causata da diverse specie di Colletotrichum e si manifesta come un’evidente macchia di marciume sulle mele in pieno campo.
Sebbene la GLS e l'ABR possano essere causate dagli stessi patogeni fungini, secondo le attuali conoscenze si tratta di due patologie diverse, che possono manifestarsi anche contemporaneamente nello stesso appezzamento però seguono un'epidemiologia diversa.
Attività di ricerca su GLS presso il Centro di Sperimentazione Laimburg
Subito dopo il primo rilevamento della GLS nel 2020, presso il Centro di Sperimentazione Laimburg sono iniziate intense attività di ricerca. Il gruppo di lavoro Fitopatologia ha isolato il fungo dalle macchie delle foglie e dei frutti e ha rapidamente identificato la specie Colletotrichum chrysophilum. A ciò è seguita la prova scientifica che questa specie causa la malattia (Deltedesco & Oettl, 2022) . L'identificazione esatta della specie è complessa, ma è essenziale per sviluppare strategie di controllo mirate. Infatti, altre ricerche extraeuropee hanno dimostrato che l'efficacia dei fungicidi dipende notevolmente dalla specie di Colletotrichum. Le prime misure di controllo della GLS in pieno campo sono state condotte dal gruppo di lavoro Valutazione Fitofarmaci del Centro Laimburg nelle stagioni di vegetazione 2022 e 2023 e l’analisi preliminare ha già dato indicazioni sulle possibili strategie. Anche il gruppo di lavoro Agricoltura Biologica del Centro ha iniziato a condurre diverse prove di trattamento in campo.
Sono stati effettuati, inoltre, dei test sulla suscettibilità dei frutti all'infezione con C. chrysophilum su 24 varietà di mele coltivate in Alto Adige (l’analisi dei dati è in corso). Oltre a ciò, è stato sviluppato un metodo per l'infezione artificiale di semenzali di melo in serra, in modo da poter simulare in vivo diverse condizioni di infezione (attività necessaria per una corretta e approfondita conoscenza scientifica sulla patologia.
Una serie di ulteriori esperimenti condotti dai vari gruppi di lavoro del Centro di Sperimentazione Laimburg è attualmente in fase di pianificazione e saranno attuate nel prossimo futuro, anche in collaborazione con istituti di ricerca nazionali e internazionali.
Cooperazione con altri istituti di ricerca
La stretta collaborazione tra il Centro di Sperimentazione Laimburg e il Centro di Consulenza per la Fruttiviticoltura dell’Alto Adige è di grande importanza anche per questa patologia fungina emergente. Inoltre, sin dalla prima comparsa della GLS, è stato avviato un vivace scambio con personale di ricerca e di consulenza delle altre aree di produzione di mele. Anche per la GLS è essenziale un approccio multidisciplinare: l'obiettivo deve essere unire le forze e lavorare insieme per contrastare questa sfida per la melicoltura.
Immagini

Sintomi: Come primi sintomi della GLS appaiono delle macchie fogliari necrotiche, di colore marrone-violaceo.

Foglie in stato avanzato: In uno stadio avanzato, si sviluppa una pronunciata clorosi delle foglie.

Macchie dei frutti: Le tipiche macchie dei frutti della GLS hanno un diametro di circa uno a tre millimetri, sono di colore bruno-rossastro e possono essere leggermente infossate, qui sulla varietà Golden Delicious.

Sito di infezione: Prima che si sviluppi il colore rosso della copertura, spesso compare un anello (anche detto “alone”) viola intorno al sito di infezione, qui sulla varietà Rosy Glow(cpvr).

Defogliazione: La GLS è caratterizzata da una precoce, quasi completa defogliazione degli alberi entro poche settimane dalla comparsa delle prime macchie fogliari.
Colletotrichum chrysophilum: Un isolato di Colletotrichum chrysophilum su terreno di coltura.

Marciume amaro: Nell'autunno del 2023 è stato osservato per la prima volta nei meleti altoatesini il marciume amaro (apple bitter rot; ABR), anch'esso causato da specie di Colletotrichum.